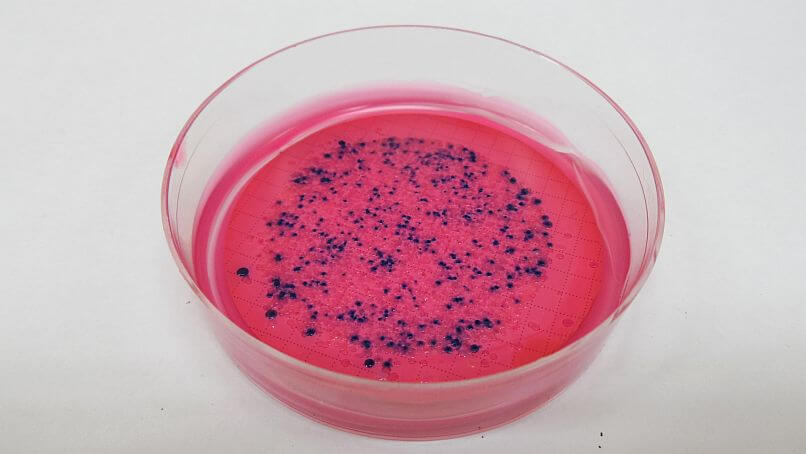
E. coli

Welcome to Near North Lab
Founded in 1989, Near North Lab Inc. provides a variety of environmental services. The company specializes in the areas of microbiological and chemical analysis of drinking water and waste water. Located in North Bay, Ontario, Near North Lab is one of the few independently owned and operated environmental testing facilities in Canada thus ensuring our clients of third party objectivity.
Our testing services include microbiological, physical chemical, inorganic chemical, and some organic chemical analyses. Staff can assist with project designs and R&D efforts such as bench top treatability studies. We have qualified and experienced technologists for on-site sampling and field-monitoring programs if needed; some also hold the Ontario Ministry of the Environment, Conservation and Parks (MECP) Water Quality Analyst (WQA) certification.